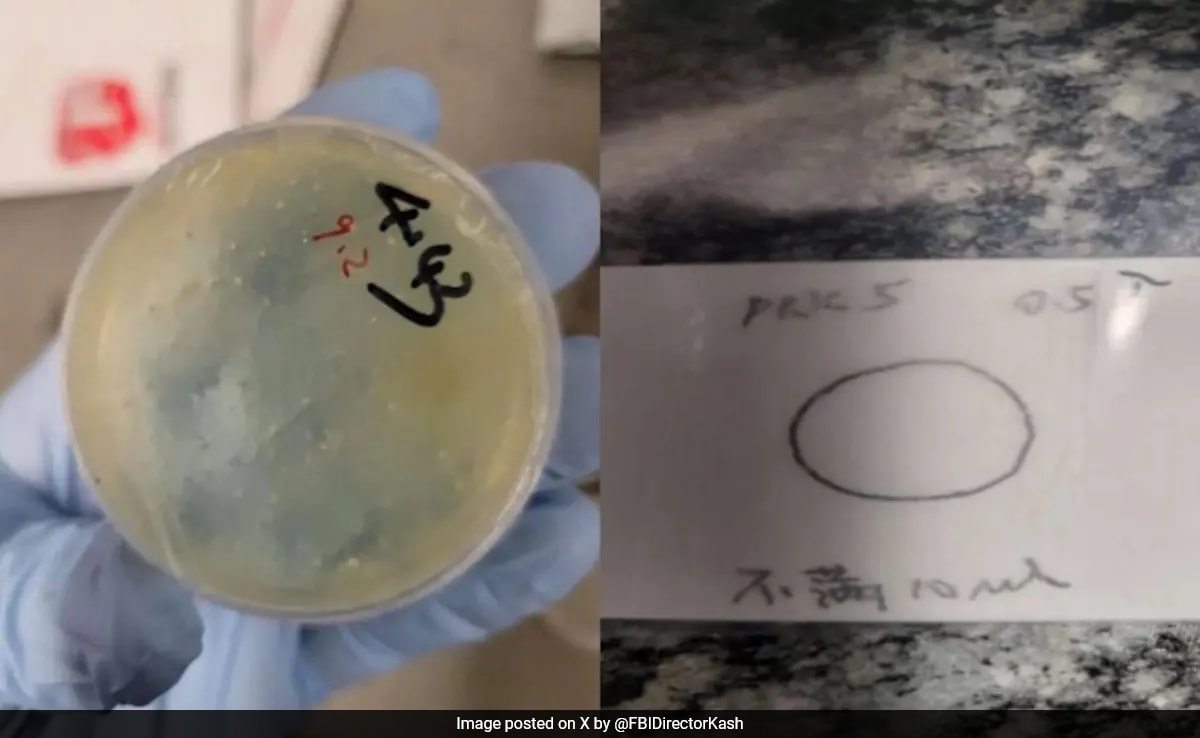
Бързо четене Резюме е генериран от AI прегледано Newsroom Китайски

... средно по 28,8 точки, 3,9 асистенции и 3,5 борби. Голдън Стейт Уориърс е осми в класирането на Запад с баланс от 10 победи и 10 загуби.
Малко Седмица - Новини
Постепенно намаление на американците които подават молби за безработни отбелязано
...... 223 750.Общият брой на американците, подали молби за обезщетение за безработица за седмицата, завършваща на 15 ноември, се е увеличил с 7000 до 1,96 милиона.
ВАШИНГТОН AP — Броят на американците кандидатстващи за обезщетения за
...... с 1000 до 223 750.Общият брой американци, подали документи за обезщетения за безработица за седмицата, приключваща на 15 ноември, нарасна със 7000 до 1,96 милиона.
Американският президент Доналд Тръмп даде на Украйна по малко от седмица
...... – всички дългогодишни изисквания на Кремъл.Така, ключовите части на предложението, подкрепено от Вашингтон, съответстват на предишните искания на Москва и преминават „червените линии“ на Украйна.
Саймън Лач адвокат в малко градче във Вирджиния едва смогва
...... Вие можете да допринесете за нашия стремеж към истината, неприкривана от финансови зависимости. Можете да помогнете единственият поръчител на съдържание да сте вие – читателите.
Cam Skattebo събира хардуер за да върви с тъчдауните си
...... кариерата. "Докато спечелим мача, тогава съм щастлив. Можех да отида за 25 ярда и нула тъчдаун и пак да съм щастлив, че спечелихме." Разгледайте повече
Въпреки многобройните предизвикателства пред които е изправено киното през 21 ви
...... значително повторно пускане в Китай доведе до това, че „Avengers: Endgame“ беше свален от първото място отново от сините извънземни на „Avatar“ през 2021 г.
По указания на Негово Височество шейх Мохамед бин Рашид Ал
...... на ОАЕ, емирство Дубай и Dubai Humanitarian в подкрепа на международната хуманитарна реакция и гарантиране, че навременната помощ достига до засегнатите общности в Афганистан.източник: www.wam.ae
Несигурността около първото домакинство на Барселона за сезона в Ла
...... допълва, че през последните дни са проведени редица технически огледи, за да се удостовери, че стадионът е безопасен и може да приеме двубоите напълно безопасно.
Spirit Airlines приключва полети в дузина по малко от седмица
...... Powerball Jackpot DataNfl Week 1 Прогнози. Company studiositemap за ParamountAdvertise с Paramountjoin Нашият талант CommunityHelpfeedback Copyright © 2025 CBS Interactive Inc. Всички права запазени. Преглед
u s military fighter jets were scrambled on Tuesday to track
...... Норад заяви, че е изпратил боен въздушен патрулен отдел за наблюдение на множество руски военни самолети в Арктика. Liz Fliz Friden допринесе за този доклад.
До 25 август близо 1600 ученици от област Плевен които
...... Tube канала на НАП, сайта на приходната агенция или на телефони: 0700 18 700; +359 2 9859 6801 на цена, съгласно тарифата на телефонния оператор.
Разрастващ се списък от държави започва да експериментира с четиридневна
...... просто нов график, а внимателна стратегия и вътрешна културна трансформация.Една от основните бариери остава корпоративната култура с вкоренени представи за работа и продуктивност, отбелязват експертите.
Броят на загиналите в сирийската провинция Суейда населена предимно с
...... външни участници, на фона на етническо и религиозно напрежение. Според наблюдатели това е една от най-жестоките ескалации в района от началото на конфликта в Сирия.
A 42 year old Trinamool Congress TMC leader was shot dead in
...... 10 at English Bazar in Malda.(Except for the headline, this story has not been edited by NDTV staff and is published from a syndicated feed.)
Когато имаш много пари често и губиш много пари В
...... плановете си в следващите 20 години да разпредели почти цялото си богатство за различни благотворителни каузи. Така че явно ще пада все по-надолу в класацията.
Вашингтон AP Броят на американците кандидатстващи за обезщетения за безработица падна
...... години вече е по -висока от общия процент на безработица, а разликата между двете е най -широката, в която е била повече от 30 години.
възможността музикален магнат Шон Диди Комбс да свидетелства в процеса
...... пет, оценка, която вероятно няма да се прилага, ако Комбс свидетелства. Свидетелство от две от бившите му приятелки консумира две от шестте седмици на процеса.
Данни на Евростат разкриват драстични промени в работните навициЕвропейците постепенно
...... час, като в някои случаи надхвърли два часа. Белгия и Люксембург също отбелязаха значителен спад, като седмичното работно време се съкрати с по 2,5 часа.
Потапяме се под земята в мистичните римски катакомби и
...... — защото Travellove е мястото, където всяка седмица започва с нова доза вдъхновение за пътешествия и живот без граници! Последвайте ни в Instagram и Facebook за още полезна информация. Очакваме те!
Потапяме се под земята в мистичните римски катакомби и ухаещата
...... с нас — защото е мястото, където всяка седмица започва с нова доза вдъхновение за пътешествия и живот без граници!Последвайте ни в и за още полезна информация.Очакваме те!
Потапяме се под земята в мистичните римски катакомби и
...... — защото Travellove е мястото, където всяка седмица започва с нова доза вдъхновение за пътешествия и живот без граници! Последвайте ни в Instagram и Facebook за още полезна информация. Очакваме те!
Бързо четене Резюме е генериран от AI прегледано Newsroom Китайски
...... безмилостно да подкопае американските изследователски институции. Но ФБР и други федерални агенции са съсредоточени върху разрушаването на подобни операции за контрабанда на патогени, добави той.
Седем души бяха простреляни и ранени трима от които тежко
...... след като си тръгнаха от събитие в Еврейския музей. Ярон Лишински и Сара Милгрим са били двойка, на която е предстоял годеж само след седмица.
За 130 часа работа на камерите за скорост са заснети
...... инцидент, при който загина 12-годишната Сияна, а дядо ѝ бе тежко ранен. Тази катастрофа бе повод за протести в страната срещу лошото състояние на пътищата.
Експертен планински водач постави четирима свои клиенти на върха на
...... за изкачване на Еверест тази година. Приблизително половината от тях са успели и останалите вероятно ще опитат изкачването им в рамките на следващите няколко дни.
За по малко от седмица с осъдителна присъда приключи разследване за
...... установено, че е кокаин с тегло 0,53 грама.Определението на Районен съд – Търговище за одобряване на споразумение е окончателно и присъдата влиза в сила незабавно.
снимка Walmart Представяме си че представяте синя и жълта цветова
...... бюджета на официалните радости предлага комфорт и солидна ефективност по време на ежедневни или конкурентни игри за игри. Купете сега $ 49,99 $ 25,89 обновяване
accuweather каза че може да има дъжд до пет дни
...... реки в небето - това транспортира по -голямата част от водните пари извън тропиците. еквивалентен на средния поток вода в устието на река Мисисипи. ”
Броят на американците които търсят обезщетения за безработица падна скромно
...... 000 нови приложения. Броят на американците, които получават обезщетения за безработица за седмицата на 22 март, се е увеличил с 56 000 до 1,9 милиона.
Най малко 2500 руски и украински войници умират всяка седмица
...... Лавров."Подкрепяме елиминиране на причините за кризата чрез преговори, които да доведат до мир и стабилност в Евразия и света", казва китайският първи дипломат, съобщава БНР.
Най малко 2500 руски и украински войници умират всяка седмица –
...... министър Сергей Лавров.„Подкрепяме елиминиране на причините за кризата чрез преговори, които да доведат до мир и стабилност в Евразия и света“, казва китайският първи дипломат.
Най малко 2500 руски и украински войници умират всяка седмица
...... министър Сергей Лавров. "Подкрепяме елиминиране на причините за кризата чрез преговори, които да доведат до мир и стабилност в Евразия и света", казва китайският първи дипломат.
Най малко 2500 руски и украински войници умират всяка седмица
...... "Подкрепяме елиминиране на причините за кризата чрез преговори, които да доведат до мир и стабилност в Евразия и света", казва китайският първи дипломат, съобщава БНР.
Днес беше ден на размествания в Народното събрание Оказа се
...... парламента. Неговият колега Танер Мюмюн обаче светкавично се оттегли от мястото, което заема от същата листа, и така Анастасов получи възможност да заеме мястото му.
Близо 9 градуса достигна средната денонощна температура в района на
...... море. Но и там, както и у нас, след средата на следващата седмица, ще започне ново затопляне, което вече трайно ще установи пролетта над Европа.
Броят на американците подадени за обезщетения за безработица падна леко
...... на анализаторите на нови приложения за 226 000. Американците, получаващи обезщетения за безработица за седмицата на 1 март, паднаха с 27 000 до 1,87 милиона.
Докато 2 та седмица в NFL видя много вълнение също видя
...... в първите две игри, най -много в NFL. ___ Тази колона е предоставена на Associated Press от BetMGM онлайн спортна книга. ___ ap спорт: https://apnews.com/hub/sports
if DIR hasOwnProperty sectionId DIR sectionId includes 136 Hide ads
...... на 2024 г. Министерството на транспорта също подкрепи инициативата, а служебният министър Красимира Стоянова заяви: "Това е безспорното име, което трябва да носи националното ни летище"
Phoenix AP Членовете на племе в Аризона призоваха федерален
...... че този въпрос може да получи голямо внимание от съда, преди да бъдат предприети неотменяеми действия, - каза тя. ____ sonner съобщава от Рено, Невада
Испанското правителство одобри законопроект предвиждащ намаляване на стандартната работна седмица
...... сектори като хотелиерство, комуникации, търговия и селско стопанство. В останалите отрасли на испанската икономика намаляването на работното време вече е залегнало в колективните трудови договори.
От началото на данъчната кампания за 2025 г в бюджета
...... Затова, ако имате невнесени данъци за минали години, системата ще отчита първо тяхното покриване. При забавяне на плащанията върху дължимите суми се трупа законна лихва.
ХАЙДЕРАБАД Индия AP — Проливни мусонни дъждове и наводнения убиха
...... трета от Пакистан, убивайки 1739 души и причинявайки щети за 30 милиарда долара.___Авторът на Associated Press Абдул Сатар в Куета, Пакистан, допринесе за този доклад.
Ето сценарий за който Алабама не беше подготвена през Седмица
...... за този доклад.___Получавайте сигнали за анкети и актуализации за Топ 25 на AP през целия сезон. Запишете се тук. AP колежански футбол: https://apnews.com/hub/ap-top-25-college-football-poll и https://apnews.com/hub/college-football
if DIR hasOwnProperty sectionId DIR sectionId includes 136 Hide ads
...... "); if ( DIR.hasOwnProperty("sectionId") && DIR.sectionId.includes(136) ) { // Hide ads when get PR ZONE document.getElementById("native-wrap-1712677954281").style.display = "none"; } } Как оценявате вашата 2024 година?






)

,fit(968:545)&13:14:07)